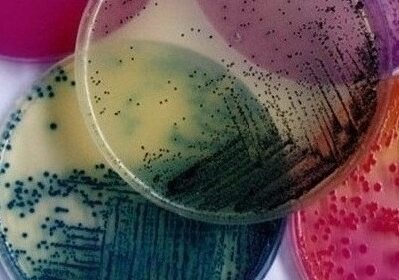
microbio 17744

Chaque maillon de la chaîne alimentaire est concerné par les analyses microbiologiques en laboratoire.
Pour faire face aux risques encourus, CHELLALI LAB vous propose une large gamme d’analyses microbiologiques des aliments pour détecter par exemple :
- Flores aérobies 30°C
- Entérobactéries
- Escherichia coli
- Staphylococcus aureus
- Clostridium perfringens
- Levures
- Moisissures
- Salmonella
Ces diverses analyses permettent aux acteurs de la filière agroalimentaire de vérifier la qualité nutritionnelle et la conformité de leur production alimentaire.
Nous vous proposons un large panel d’analyses physico-chimiques : (pH, poids/ contenance, densité, extrait sec, humidité, acidité, Cendres, Matière grasse , matière grasse/ matière sèche, Protéines, Extrait sec dégraissé, Matière protéique/ extrait sec dégraissé, Brix, Indice de réfraction, matière volatile, %pulpe, %fruit, teneur en vit C, solubilité, indice d’acide, indice d’iode, indice de saponification, indice de peroxyde, sucres totaux, sucres réducteurs, saccharose, teneur en caféines, Lactose, cellulose, teneur en sel, Mesure du taux de foisonnement, iode dans le sel.)
– Analyse avant production: Pour valider que votre produit est conforme à vos exigences ainsi qu’aux exigences légales.
– Analyse en fin de production: Pour vérifier que tous les paramètres critiques pour la vente sont respectés.
Nous pouvons vous apporter une aide précieuse pour la valorisation nutritionnelle de vos produits alimentaires.
L’étiquetage des produits alimentaires fournit aux consommateurs des renseignements utiles sur les avantages nutritionnels et les bénéfices sur la santé des denrées alimentaires.
CHELALLI LAB apporte son expertise pour aider les professionnels de l’agroalimentaire :
– à se conformer à la réglementation de plus en plus complexe en matière d’étiquetage,
– à répondre à la prise de conscience des consommateurs en matière de santé.
L’ajout de la composition des denrées alimentaires sur l’emballage informe et rassure le consommateur qui s’intéresse de plus en plus au contenu des produits.
Les informations devant figurer sur l’étiquette d’un produit sont de deux types décrits ci- dessous :
- Etiquetage alimentaire Groupe 1 :
Valeur énergétique(Kj et Kcal), protéine, Glucides et Lipides - Etiquetage alimentaire Groupe 2 :
Valeur énergétique(Kj et Kcal), protéine, glucides dont sucres, lipides, fibres alimentaires, sodium
Les résultats sont exprimés en g/100g ou g/100ml. Ils peuvent également être exprimés par emballage ou portion. Les teneurs en vitamines et sels minéraux doivent être exprimés en pourcentage de l’Apport Journalier Recommandé (AJR).
Pour comparer un produit par rapport à la concurrence et le faire évaluer par un panel de consommateurs.